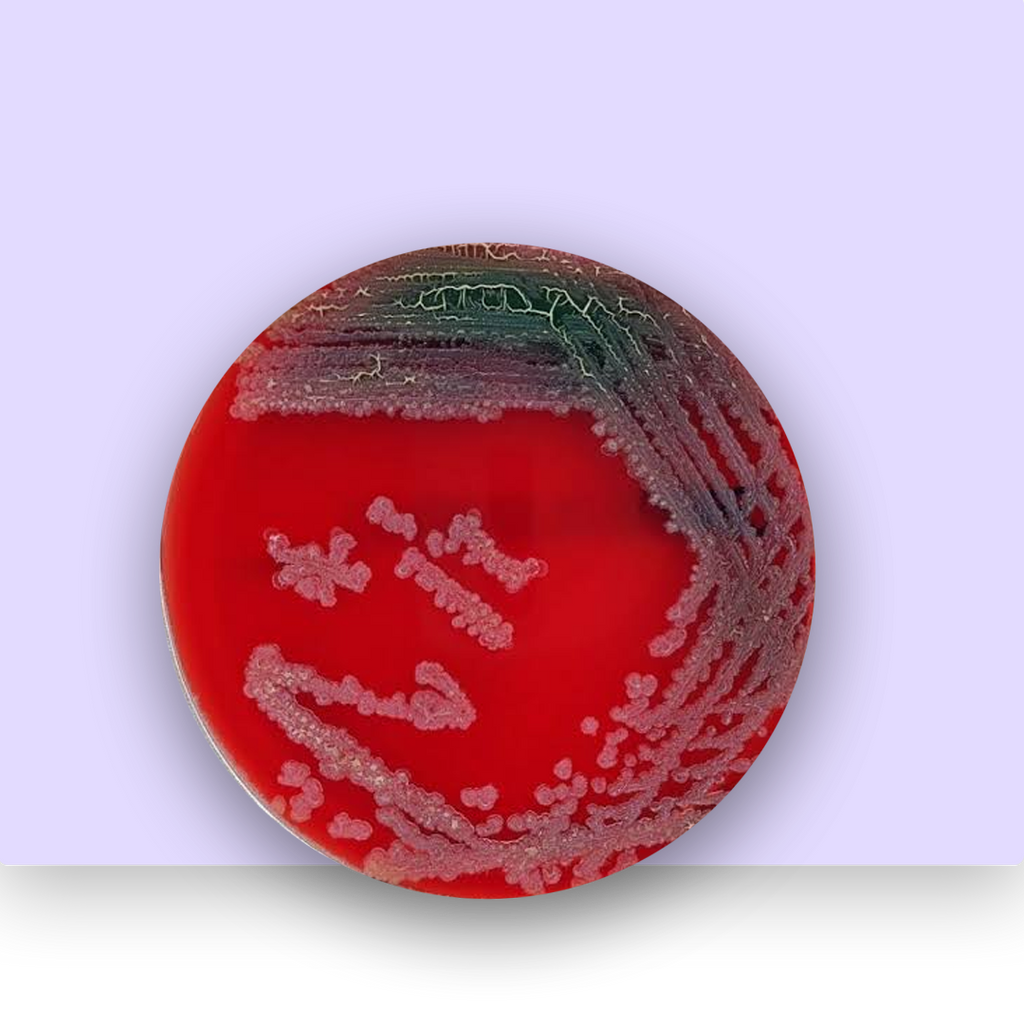

Spor
Benefits
Know your supplements
A spore-based probiotic supplement designed for gut resilience, digestive balance, and immune modulation. It survives stomach acid to deliver maximum benefits to the gut microbiome.
Ingredients
Meticulously crafted supplements
From carefully selecting only the best, scientifically validated ingredients to ensure potency and effectiveness, our every supplement undergoes a rigorous formulation and manufacturing process, meeting the highest standards of quality and safety.
Taking Spor consistently can lead to noticeable improvements in your health:
Week 1
Improved digestion & better stool regularity
Week 2
Strengthened gut microbiome & reduced bloating
Week 3
Enhanced immune response & reduced gut inflammation
Week 4
Optimized gut barrier function & better nutrient absorption


Spor
Rs. 1,200.00